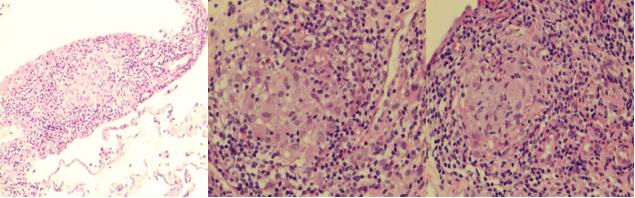
肺部陈旧病灶会变大么,肺部病灶1.2厘米严重吗

前言
「PCCM疑难病例讨论」直播在广州医科大学附属第一医院 广州呼吸健康研究院进行。本次病例讨论由叶枫教授主持,李*途征**博士进行病例汇报。在病例讨论中除了各位PCCM学员发表各自的见解外,我们也能聆听到来自广州呼吸健康研究院各位大咖,如李时悦,周承志,张清玲,刘春丽,程璘令,卓超等教授,广医一院的影像学专家曾庆思主任,微生物学专家苏丹虹主任,病理学家顾莹莹主任,药学专家蒙晓主任的精彩分享。
该患者的主要临床症状为咳嗽、咳血丝痰伴发热,肺部影像学表现为右下肺实变团块影,在治疗过程中病灶一度吸收好转,但随后又再次增大。在这种情况下,我们该如何厘清诊断思路、做出诊断和鉴别诊断?本病例主要目标在于培养PCCM学员的临床诊断思维,除了线下的学员外,也吸引了2.57万人次的线上读者。
患者,刘XX ,男,35岁,办公室职员,广东梅州人,2018年6月入院。
主诉: 反复咳嗽、咳痰,伴发热7月余。
第一阶段
现病史: 患者7月余前劳累后出现咳嗽、咳痰,阵发性咳嗽,无昼夜规律,白痰为主,偶咳血丝痰,伴发热,最高体温39.0℃,无畏寒,寒战。于当地医院就诊,胸部CT检查示双肺多发斑片状渗出及实变影,气管镜检查示气道慢性炎症,BALF病原学检查阴性。诊断「肺部感染」,予「莫西沙星」抗感染治疗后热退,建议行右肺病灶活检,但病人拒绝并出院。出院后患者在家服用中药治疗。
2018-03-03复查胸部CT,提示右肺病灶较前略有增多,遂于当地结防所就诊,考虑「继发性肺结核」可能,予「HRZE」抗结核治疗1个月。患者自觉咳嗽、咳痰无改善,仍间断发热,复查胸部CT提示病灶较前无吸收。2018-5至广州某三甲医院就诊,查血T-SPOT(-),行气管镜提示慢性炎症改变,肺泡灌洗液(BALF)的X-Pert(-),新型隐球菌荚膜多糖抗原(+),考虑诊断肺隐球菌病,予氟康唑 400mg 治疗。1个月后,至我院门诊就诊,复查胸部CT提示病灶无明显变化,为进一步诊治收住我科。患者起病以来,精神、胃纳、睡眠可,大小便如常,体重降落约7kg。
既往史: 患者自幼乙肝病毒携带,平素口服护肝药物及维生素;先天性马蹄肾,肾功能良好。否认高血压、糖尿病、冠心病等慢性病史。
个人史: 否认烟酒嗜好;无食生鱼史。
过敏史: 否认药物食物过敏史。
婚育史: 已婚,配偶体健,育有1子。
入院查体: 体温38.3℃,脉搏102次/分,呼吸18次/分,血压121/78mmHg。发育正常,营养中等,呼吸平顺。皮肤粘膜无黄染,全身浅表淋巴结未触及肿大。胸廓无畸形,呼吸节律对称,叩诊呈清音,听诊双肺呼吸音粗,右下肺可闻及湿啰音。心界不大,心率102次/分,律齐,未闻及病理性杂音。腹平,软,未及包块,无压痛,无反跳痛,肝脾肋下未及肠鸣音存在。生理反射存在,病理反射未引出。
外院辅助检查: 2017-12-8当地医院:血常规:WBC 5.5X109/L (4-10), NEU% 69.1% (40-70), NEU 3.8 X109/L (1.8-8), LYMPH 0.7X109/L (0.9-5.2), MONO 1.0 X109/L (0.16-1.0), HGB 153g/L (120-160), PLT 180 X109/L (100-400)。C反应蛋白:8.29 mg/L;肝功能:ALT 103 U/L,AST 52U/L;血癌胚抗原(CEA):3.08ng/ml;血T-SPOT:阴性;痰抗酸杆菌涂片:阴性;痰培养:未见细菌和真菌生长。
2018-5广州某三甲医院:肺泡灌洗液新型隐球菌荚膜多糖抗原(+);X-Pert:未检测到结核分枝杆菌。
外院胸部影像学(CT):

病例特点总结
青壮年男性,慢性病程;咳嗽、咳血丝痰伴发热为主要症状;既往有「先天性马蹄肾」,「乙型肝炎病毒携带」病史;体查:体温:38.3℃,听诊双肺呼吸音粗,右下肺可闻及吸气相湿啰音;外院检查提示:淋巴细胞降低,单核细胞升高;C反应蛋白升高;转氨酶升高;新型隐球菌荚膜多糖抗原阳性;T-Spot和X-Pert阴性;外院胸部CT提示炎性病变;外院曾予抗感染,抗结核治疗1月,抗隐球菌治疗1月,效果欠佳。
入院初步诊断
1、肺隐球菌病;2、肺结核;3、非结核分枝杆菌肺病;4、肺癌;5、机化性肺炎
入院后完善相关检测
血常规:WBC 6.98X109/L, NEU% 51.5%, NEU 3.6X109/L, LYMPH 0.7X109/L (0.9-5.2), MONO 1.0 X109/L (0.16-1.0), HGB 153g/L (120-160), PLT 180 X109/L (100-400)。
尿常规和大便常规未见异常。
肝功八项,血气分析,CX3生化八项,心梗鉴别六项,凝血功能,肾功能等未见异常。
血传播八项 :乙肝表面抗原(化学发光法) 20.31IU/mL;HBV-DNA 3.62X103 IU/mL;HIV阴性。
血沉 12mm/h。
肺肿瘤五项:神经元特异性烯醇化酶 16.81 ng/mL,癌胚抗原 2.53 ng/mL,糖类抗原125 21.42 U/mL,糖类抗原153 10.43 U/mL,非小C肺癌相关抗原 2.19 ng/mL。
风湿三项:阴性;抗核抗体普十一项:阴性;血管炎五项:阴性;抗心磷脂抗体:阴性。
免疫八项:免疫球蛋白G、补体C3,C4正常。
TBNK检测: T淋巴细胞百分比(CD3+) 77.1 %,辅助T细胞(Th)(CD3+CD4+) 31.6 %,抑制T细胞(Ts)(CD3+CD8+) 36.1 %,辅助T细胞/抑制T细胞(Th/Ts) 0.88 %,B淋巴细胞百分比(CD3-CD19+) 15.3 %,自然*伤杀**细胞百分比(CD3-CD16+CD56+) 7.3 %。
结核与非结核分枝杆菌感染相关指标: 5UPPD 皮试:阴性;痰结核菌涂片:阴性;痰结核分枝杆菌核酸检测(TB-DNA):阴性;痰结核分枝杆菌快速分子鉴定( X-pert ):阴性;血结核感染T细胞检测(免疫斑点法)(T-spot):抗原A(ESAT-6)孔 0.00 个,抗原B(CFP-10)孔 0.00 个;痰分枝杆菌菌种鉴定(DNA微阵列芯片法):阴性。
细菌感染相关指标: PCT:<0.05ng/mL;C反应蛋白 2.25 mg/dL;细菌涂片阴性;痰细菌培养阴性。
真菌感染指标: 血真菌1-3-β-D-葡聚糖定量检测(G试验):<10 pg/mL;血半乳甘露聚糖检测(GM试验):0.351 ug/L; 血隐球菌抗原>100.0 ug/L(≥8.0 ug/L 为阳性) ;痰涂片:未见真菌;真菌培养:阴性。
我院胸部CT(2018-6-6)

纤维支气管镜检查:

气道腔内未见异常
予超声小探头伸入右下叶背段支气管未探及明显超声实性低回声区,于此行活检及刷检。
支气管肺泡灌洗检查结果:
•细菌涂片二项阴性
•TB-DNA阴性;肺泡灌洗液X-pert阴性;刷检找抗酸菌均阴性
•曲霉菌抗原(GM试验)检测阴性
• 隐球菌抗原:11.389ug/L
•一般细菌培养,结核培养阴性
• 真菌培养:新生隐球菌(药敏结果:对氟康唑、伏立康唑、氟胞嘧啶敏感)
苏丹虹教授就隐球菌培养的技术进行解说
肺组织病理结果:

(右下叶背段)送检肺组织,肺泡腔内见少许组织细胞渗出,部分间质增宽,个别淋巴细胞浸润,碳尘沉着,局灶可见一些组织细胞聚集, 组织改变为肺间质性炎症,未见肉芽肿及肿瘤。
免疫组化结果:CK(上皮+),LCA(CD45)(-),CD163(组织细胞+);
特殊染色结果:AB(-),抗酸(-),PAS(-),GMS(-)。
腰椎穿刺及脑脊液检测结果:
腰穿的脑脊液压力:108mmH2O
留取脑脊液完善相关检查:
•脑脊液常规检查:颜色 无色,凝块 无,透明度 清晰,潘氏试验 阴性,红细胞 87*10^6/L,白细胞 1*10^6/L
•脑脊液生化:脑脊液蛋白定量 0.24 g/L,脑脊液氯化物 135.8 ↑ mmol/L,脑脊液糖 4.07 mmol/L
•脑脊液隐球菌抗原 3.389ug/L(ELISA;>10ug/L),胶体金:阴性
•脑脊液隐球菌墨汁染色
•脑脊液真菌培养:阴性
最终诊断
1、肺隐球菌病
2、先天性马蹄肾
3、慢性乙型病毒性肝炎
治疗方案:
1、氟康唑 400mg qd
2、乙肝病毒的抗病毒治疗:恩替卡韦
3、定期随诊
第二阶段
定期随访: 患者无发热,治疗初期咳嗽、咳痰症状好转。但治疗过程中,曾出现咯血,5-10ml不等,暗红色。2019年2月起发现肾积水,继而尿酸升高,肾功能不全,使用「别嘌醇」,1个月后发现白细胞为0.9×109/L,予停用,使用升白片治疗2月,自述白细胞回复正常。2019-4出现咳嗽、咳痰加剧再次入院。
血隐球菌抗原监测:
|
日期 |
2018-6 |
18-10 |
2019-1 |
19-3 |
19-4 |
19-5 |
|
血隐球菌抗原 |
>100 |
31.109 |
8.154 |
7.182 |
<3.2 |
4.832 |
判断标准≥8.0 ug/L 为阳性;<5.0为阴性;5.0-8.0建议临床视察
胸部CT的变化情况:

本病例的疑问: 为什么患者在血隐球菌抗原降落的过程中,出现临床症状和影像学改善不理想?
结合患者的病情和文献的报道,我们推测有以下的原因:
1、氟康唑耐药
2、免疫重建炎症反应
3、隐球菌合并肺癌
4、非感染性疾病(肺癌?血管炎?机化性肺炎?)
5、混合感染(隐球菌合并其他特殊病原体)
同时完善相关检测:
血常规:WBC 3.97X109/L, NEU% 55.7%, NEU 2.2X109/L, LYMPH% 35.3%, MONO% 7.7%, HGB 139g/L, PLT 182 X109/L。
尿常规和大便常规未见异常。
肺肿瘤五项:神经元特异性烯醇化酶 16.54 ↑ ng/mL,癌胚抗原 2.52 ng/mL,糖类抗原125 20.53 U/mL,糖类抗原153 11.51 U/mL,非小C肺癌相关抗原 2.06 ng/mL。
血管炎指标:血管炎五项 阴性;抗心磷脂抗体 阴性。
结缔组织病指标:免疫八项,风湿三项,抗核抗体谱十一项 均为阴性。
免疫八项:免疫球蛋白G、补体C3,C4正常。
T淋巴细胞亚群及绝对计数: T淋巴细胞百分比(CD3+) 78.7 %,辅助T细胞(Th)(CD3+CD4+) 29.8%,抑制T细胞(Ts)(CD3+CD8+) 29.3%,辅助T细胞/抑制T细胞(Th/Ts) 0.76%;T淋巴细胞百分比(CD3+) 计数 1687 个/UL,辅助T细胞(Th)(CD3+CD4+)计数 638 个/UL,抑制T细胞(Ts)(CD3+CD8+) 计数843 个/UL。
结核与非结核分枝杆菌感染相关指标: 痰结核菌涂片:阴性;痰结核分枝杆菌核酸检测(TB-DNA):阴性;痰结核分枝杆菌快速分子鉴定( X-pert ):阴性;血结核感染T细胞检测(免疫斑点法)(T-spot): 阴性;痰分枝杆菌菌种鉴定(DNA微阵列芯片法):阴性
细菌感染相关指标: PCT:<0.05ng/mL;细菌涂片阴性;痰细菌培养阴性。
真菌感染指标: 血G试验:阴性;血曲霉菌抗原检测:0.457 ug/L(>0.85 ug/L 为阳性);血隐球菌抗原:<3.2 ug/L;痰真菌涂片:阴性;痰真菌培养 阴性。
专家解疑
一、是隐球菌耐药吗?
主持人叶枫 教授: 在临床上确实存在隐球菌初始就耐药的现象,但这个病例早期BALF培养提示该隐球菌对氟康唑是敏感的,因此把氟康唑作为第一选择。在抗细菌治疗过程中,存在耐药交替的情况。同样地,在某些抗真菌治疗中,比如曲霉菌的长期治疗中也有类似现象,然而在隐球菌治疗中是否有这种情况,还需要更多研究证实,下面也请卓超教授谈谈。
卓超 教授:
首先,细菌耐药和真菌耐药评估有所不同,细菌治疗失败我们往往会考虑耐药并且后面往往得到证实,但真菌耐药的概率低得多,尤其是隐球菌对唑类耐药,目前报告极少。真菌耐药存在所谓90/60法则,就是说,体外敏感,体内90%有效,体外耐药,体内仍然有60%是有效的。其次,考虑真菌耐药,首先要排除3个因素:①宿主免疫功能;②合并其他感染或者基础疾病;③所用药物剂量是否足够;在考虑排除这三个因素后,再考虑耐药。目前国内所有针对隐球菌的监测(如China Scan和CHINET)均显示,隐球菌对氟康唑的敏感性几乎是99%,国外的数据未必能套用于国内。此外,要看这个患者是否再分离到隐球菌,以及后面分离到的隐球菌耐药表现跟初始分离的菌株是否一致。隐球菌还有一个特别的地方,表面上耐药不多见,但存在异质性耐药,这是它危害最大的一个地方,隐球菌异质性耐药株的毒力比普通菌株更强。所谓异质性耐药,就是治疗过程中,在药物的压力下转为耐药,但拿到体外常规的条件培养MIC又恢复到敏感态势,这个要鉴别也很简单,在培养基里面加一点氟康唑立刻就表现出来了。
二、是免疫重建炎症反应吗?
主持人叶枫 教授: 该患者如何鉴别免疫重建综合征。
程璘令 教授:
首先这个患者是一个明确的肺隐球菌病,且治疗过程中出现肺部情况加重,需鉴别免疫重建综合征。免疫重建综合征最早是在HIV免疫抑制患者身上发现,在抗逆转录治疗过程中,随着患者免疫系统恢复,肺部反而出现症状加重。后来发现在真菌里面,比如隐球菌、PCP、曲霉,还有结核中也发现存在免疫重建综合征,尤其是隐球菌肺炎。隐球菌感染后容易出现继发免疫抑制,表现为Th1细胞减少,随着抗菌治疗起效,免疫重建过程出现肺部免疫损伤,表现为肺部症状及影像学加重,病理特征表现主要为Th1改变的肉芽肿性损伤。要想明确免疫重建综合征的诊断,首先要排除原发感染的加重或者是新发感染,同时病理出现Th1改变的肉芽肿性损伤。这个病人前期使用抗隐球菌治疗后,病灶一度改善吸收,后期才出现症状加重,病理也未见特征表现,免疫重叠综合征可能性不大。
三、是隐球菌合并肺癌吗?
主持人叶枫 教授: 近年来,感染合并肺癌及隐球菌合并肺癌时有报道,请肿瘤专家发言。
周承志 教授:
隐球菌合并肺癌,最常见的情况是,肺癌治疗过程中合并隐球菌感染,在肿瘤化疗或其他治疗过程中,免疫力降落,容易合并隐球菌感染。第二种情况是,两个同时出现,常见于外科,早期发现多怀疑原发的肺癌,活检中发现是隐球菌合并肺癌,这种需要鉴别,可能其中一些病灶并不是肺癌而是单纯的隐球菌,是可以通过药物根治的。第三种情况就是与该患者类似的,隐球菌的治疗过程较长,中间病情反复,可能合并发生了肺癌。该患者仅NSE稍微偏高,且检验结果时高时低,肿瘤可能性不大,就算有,也是低度恶性的,考虑感染可能性大。
四、是隐球菌合并血管炎吗?
主持人叶枫 教授: 感染可诱发或继发血管炎,如何考虑。
张清玲 教授:
疾病诊断过程中,除了横向评估是否符合标准,纵向视察病情变化同样重要。该患者隐球菌感染诊断明确。临床上部分在风湿科初始诊断血管炎的患者,治疗过程中加重或反复,后面发现是病原体感染模拟了血管炎的表现。血管炎分原发型与继发型血管炎,继发血管炎就是指所谓「模拟血管炎」,指继发于感染、肿瘤、其他结缔组织病的血管炎。发热、CRP及血沉升高等血管炎表现,亦可见于发热。该患者影像学以单侧肺受累为主,病理及其他风湿免疫检查均不符合血管炎典型表现,暂不考虑血管炎。但是临床上还有免疫指标阴性的血管炎,最近在研究中发现,某些EGPA患者,通过免疫荧光法、ELISA在血中均检测不到ANCA,但在呼吸道局部痰液的增敏ANCA检测阳性。此外,任何疾病都是环境和个体基因相互作用的结果,免疫系统现有临床指标并不能够全面评估患者免疫态势,该患者TBNK、免疫球蛋白、白细胞基本正常,但发生了隐球菌感染,不排除存在免疫功能障碍,比如巨噬细胞功能异常等,但这些目前不做常规评估。
刘春丽 教授:
很多感染可诱发血管炎,如葡萄球菌、链球菌、结核、真菌、病毒均有诸多报道。在血管炎的诊断中,感染诱发的血管炎也是首先要排除的,一般感染诱发的血管炎,随着感染控制血管炎也相应好转。该患者除了少量咯血外,未见全身其他部位血管炎表现,肺部亦为单一病灶,结合对治疗的反应,不太考虑血管炎。
五、是合并其他特殊病原体感染吗?
再次行纤维支气管镜检查:

•气道腔内未见异常;小探头引导下右下肺基底段灌洗和活检;
•肺泡灌洗液GM试验<0.25ug/L;肺泡灌洗液隐球菌抗原:8.701ug/L;
•肺泡灌洗液TB-DNA阴性;X-pert阴性;刷检找抗酸菌均阴性;
•细菌和真菌培养阴性
肺组织病理:
顾莹莹 教授解读:
右下肺基底段的活检,见大量淋巴细胞浸润,夹杂浆细胞,但未见明确中性粒细胞,考虑慢性炎症性细胞浸润,可见多个边界清楚的肉芽肿性病灶及多核巨细胞,小血管上未见明确血管炎改变,肉芽肿病灶未见坏死表现,以类上皮细胞为主,散在多核巨细胞,周围未见纤维组织包裹,要考虑鉴别感染与非感染性肉芽肿。该患者背景可见炎症细胞浸润,首先考虑感染,但抗酸及六胺银染色均为阴性。隐球菌可导致肉芽肿性改变,但往往比较散在,以多核巨细胞为主,多核巨细胞内常可见吞噬隐球菌孢子,该患者肉芽肿比较紧密。结节病不会出现坏死,周围可见纤维母细胞包裹,背景淋巴细胞不多,亦不会出现咯血症状,大多数患者为体检发现,影像学可见纵隔及双肺淋巴结改变,该患者不符合。患者肺泡腔未见机化,肺组织未见肿瘤及血管炎改变,整体看考虑感染可能性大,重点排查分枝杆菌,增值性结核可见肉芽肿性改变,但往往可见朗格汉斯细胞,该患者以多核巨细胞为主,考虑非结核分枝杆菌感染可能性大。
如何进行临床诊断和鉴别诊断,疑惑重重,目前的检查结果未能明确诊断,因此行进一步检查:CT引导下经皮肺穿刺肺组织活检:
肺组织mNGS检测:少量烟曲霉(序列数:4条)
肺组织病理:

肺组织病理:组织改变为慢性支气管炎伴曲霉感染。
肾功能检测:BUN:8.9 mmol/L,肌酐:164 umol/L,肌酐清除率:44 ml/min
修正诊断
肺曲霉病
慢性肾功能不全
先天性马蹄肾
CKD2期
慢性乙型病毒性肝炎
蒙晓药师 解说肾功能不全患者用药的关注事项,及抗真菌药物选择的原则。特别提到伏立康唑片剂的口服不受肾功能的限制。
治疗方案的制定:
•伏立康唑口服200mg q12h
•予以护肝对症治疗
•定期监控血药浓度、肾功能情况
伏立康唑血药浓度监测:
|
日期 |
2019-6 |
19-8 |
19-10 |
2020-5 |
|
伏立康唑血药浓度 (ug/mL) |
0.75 |
2.14 |
1.23 |
1.34 |
判断标准:>0.5 ug/mL达标
治疗后随访(胸部CT):

2021-2(停药7个月后)复查胸部CT:

本病例的诊治体会:
1、疾病明确诊断并给予针对性治疗后,需要动态随访;治疗过程病灶先小后大,要关注警惕其他病原体的感染。
2、合适的组织病理活检方式可提高临床诊断的能力。
专家点评
李静 教授 (广东省人民医院呼吸与危重症医学科科主任):
这个病例一波三折,治疗过程中病情出现反复,用了气管镜、经皮肺穿、mNGS多种检查方法,对如何判读结果做了很全面的剖析,各位相关科室专家和PCCM学员的分析也很到位,是一个很好的榜样,相信对PCCM学员会有所收获。
赵子文 教授 (广州市第一人民医院呼吸与危重症医学科科主任):
PCCM关键培训学员的临床思维。该患者年轻、肺部结节,鉴别诊断的思路是最关键的地方,通过放射、呼吸介入的方法最终明确诊断。一般认为,肺部孤立结节,不是肺癌就是结核,好像很简单,实际上,年轻人中下肺的结节,这几年常见到为免疫正常宿主的肺部真菌感染,例如隐球菌。隐球菌的诊断有点曲折,隐球菌病灶一般在外周,与肺癌有所不同,取标本比较困难。通过纤支镜超声探头可以取到一部分,偏远的外周可以用经皮肺穿刺,在这个患者身上提示我们还有一种方法就是BALF送mNGS,这3种方法可以互相补充。
田东波 教授 (清远市人民医院呼吸与危重症医学科科主任):
这个病例有一个应该反思的地方,第一次支气管镜超声探头未见病灶,仍然做了取样,出来的BALF隐球菌阳性并做了治疗,当时CT最大病灶在右下肺基底段,但我们取的是背段,而且是超声探头下未见阴影,如果当时就针对右下肺基底段取样说不定能更早明确诊断。第二个,当时该患者在基层医院常规抗感染后阴影及症状未改善,就做了一个月的抗结核治疗,后续也没有结核的证据,诊断性抗痨的指征或许需要再慎重一点,特别是在基层医院。
李时悦 教授 (广州呼吸健康研究院 副院长)
该病例主要针对PCCM学员,主要意义在于临床思维培养。头尾部分并不难理解,但中间部分,在初始治疗有效后,病情再次加重时如何鉴别是关键。一开始我们未必能明确,但在治疗过程中密切跟进病情变化,不断完善相关检查,动态视察以及综合分析是临床医生最有力的工具。现在各专业发展迅速,除了自己专业,要跟其他相关学科多沟通,比如病理,肉芽肿改变的解读,从表面上看报告并不能得到明确提示,但跟病理专家沟通后可以得到更多的信息。今晚PCCM学员发言积极,学员发言提到病人依从性,这也是一个关键,往往是造成病人失败的原因,值得我们临床关注。具体在病情上,也提示我们,真菌是目前感染的重点之一,尤其是南方地区多见,也是一个难点。

本文完
直播导演:刘迪;
*今条头日**排版:大奔